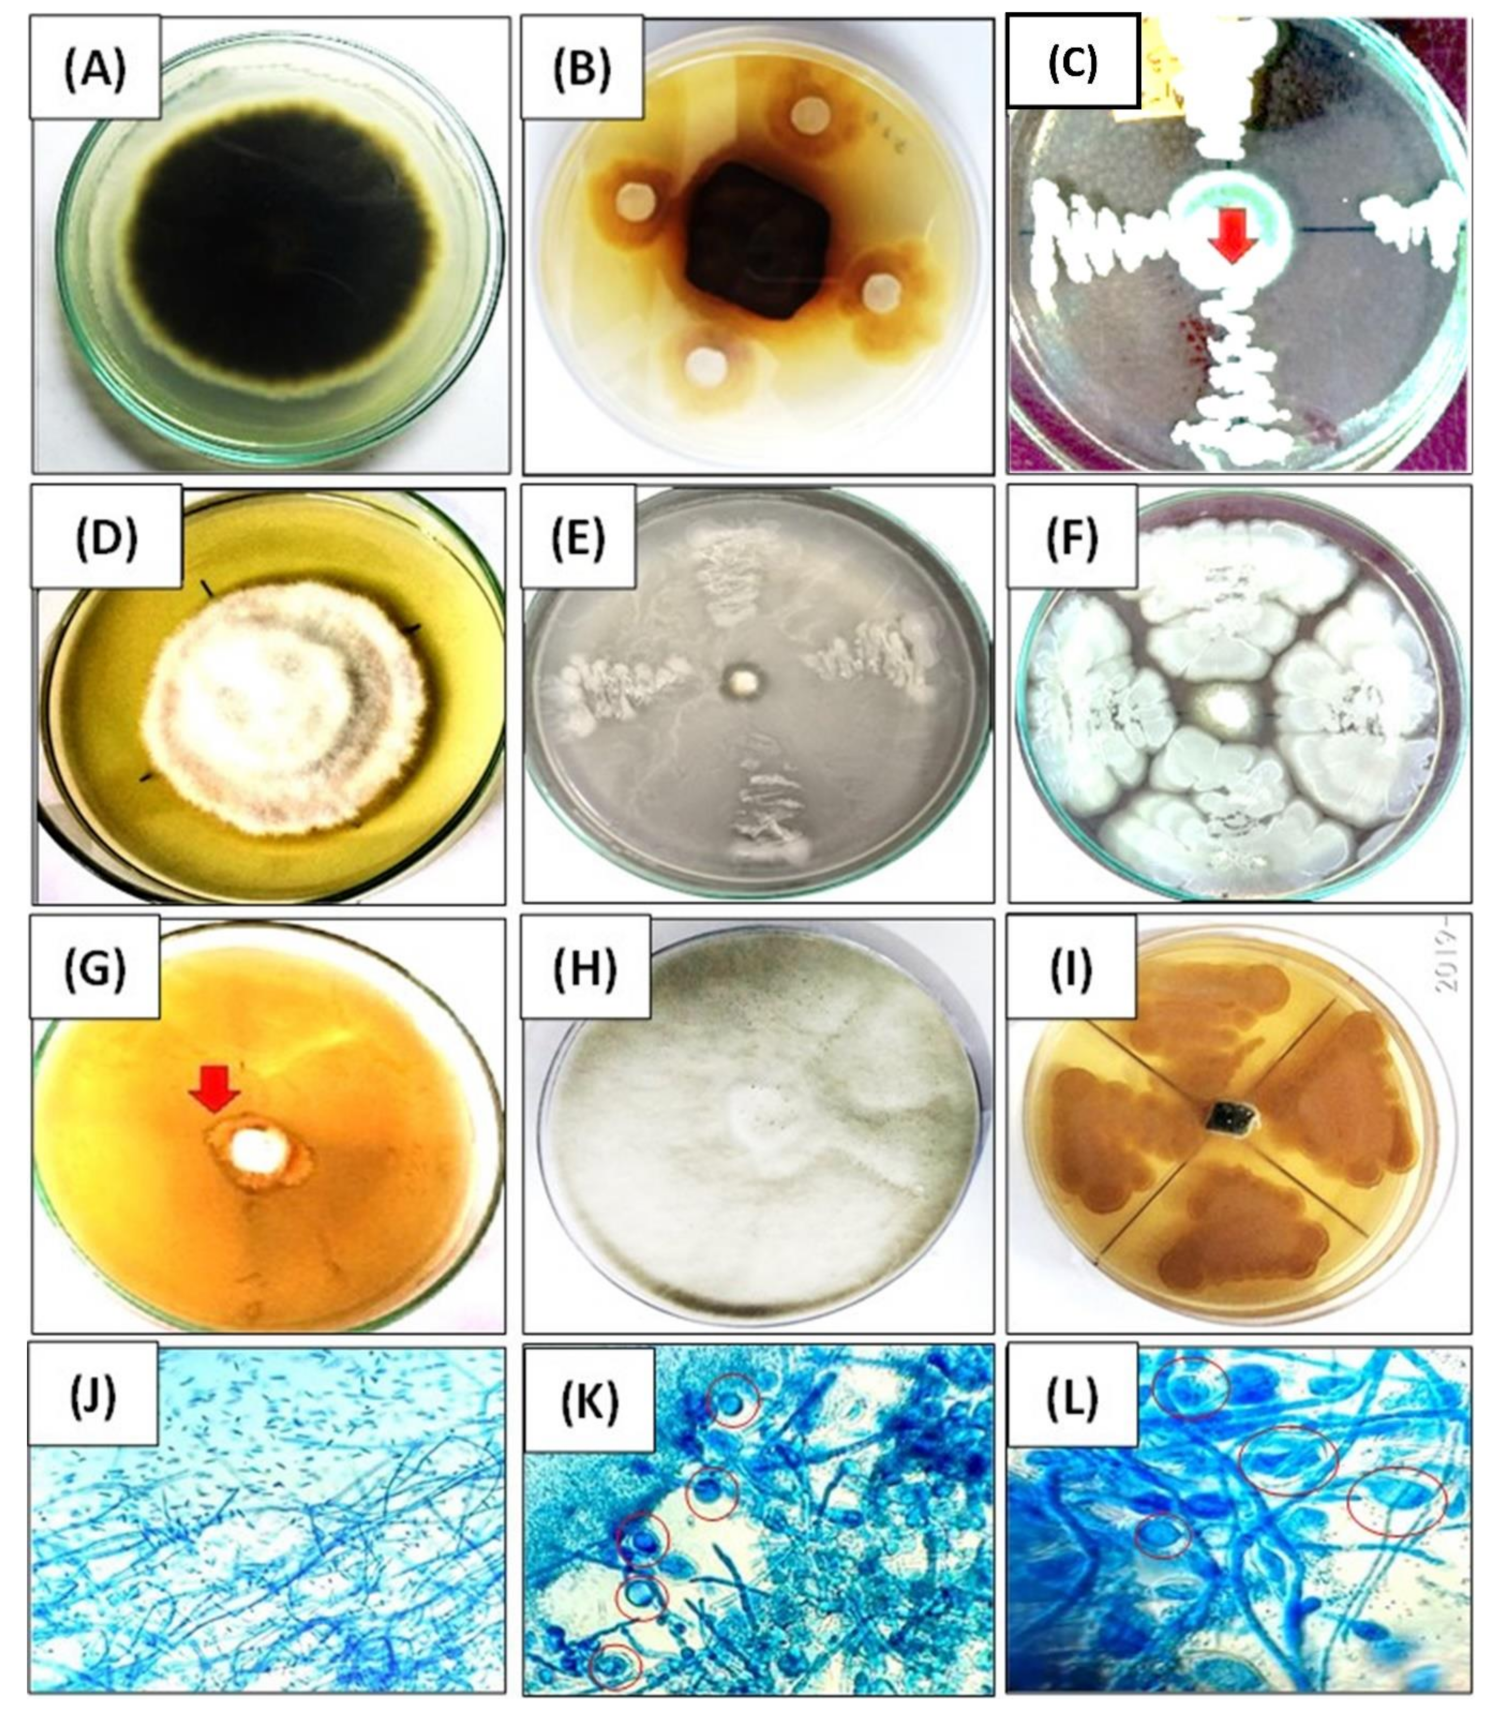
Ijerph 18 00931 g005 Ijerph 18 00931 g005

Bacterial Root Endophytes: Characterization of Their Competence and Plant Growth Promotion in Soybean (Glycine max (L.) Merr.) under Drought Stress
Abstract
1. Introduction
2. Materials and Methods
2.1. Sampling and Isolation of Endophytic Bacteria
2.2. Screening Bacterial Endophytes for Polyethylene Glycol (PEG) Tolerance
2.3. Screening Bacterial Endophytes for PGP Traits
2.3.1. Phosphate Solubilization
2.3.2. Indole-3-Acetic Acid Production
2.3.3. Ammonia Production
2.3.4. ACC Deaminase Activity
2.3.5. HCN Production
2.3.6. Enzyme Production Activity
2.3.7. Screening for Antagonistic Activity
2.4. Identification of Endophytic Bacteria
2.4.1. Biochemical Characterization
2.4.2. Molecular Characterization
2.5. Bacterial Endophytes: Soybean Seedlings Grown under Drought Stress Conditions
2.6. Analysis of Morphological, Physiological, and Biochemical Plant Parameters
2.6.1. Biochemical Analyses
2.6.2. H2O2 Content and MDA (Malonaldehyde) or Lipid Peroxidation
2.6.3. Scanning Electron Microscopy (SEM) of Roots Colonized by Endophytes
2.7. Statistical Analysis
3. Results
3.1. Screening, Identification, and Characterization of Endophytic Bacterial Isolates
3.2. Characterization of Bacterial Endophytes for Plant Growth-Promoting Activity
3.3. Screening for Antagonistic Activity
3.4. Effect of Drought-Tolerant Endophytes on Soybean Seedling Growth
3.4.1. Morphological and Biochemical Parameters
3.4.2. Correlation between Morphological, Biochemical, and Oxidative Stress Parameters
3.5. SEM Imaging of Root Endophytes
4. Discussion
5. Conclusions
Author Contributions
Funding
Institutional Review Board Statement
Informed Consent Statement
Data Availability Statement
Acknowledgments
Conflicts of Interest
References
- Gil-Quintana, E.; Lyon, D.; Staudinger, C.; Wienkoop, S.; González, E.M. Medicago truncatula and Glycine max: Different Drought Tolerance and Similar Local Response of the Root Nodule Proteome. J. Proteome Res. 2015, 14, 5240–5251. [Google Scholar] [CrossRef] [PubMed]
- Dubey, A.; Kumar, A.; Abd_Allah, E.F.; Hashem, A.; Khan, M.L. Growing more with less: Breeding and developing drought resilient soybean to improve food security. Ecol. Indic. 2019, 105, 425–437. [Google Scholar] [CrossRef]
- FAOSTAT. Statistics of the Food and Agriculture Organization of the United Nations, 2018; ISBN 9789251310120.
- Suzuki, N.; Rivero, R.M.; Shulaev, V.; Blumwald, E.; Mittler, R. Abiotic and biotic stress combinations. New Phytol. 2014. [Google Scholar] [CrossRef] [PubMed]
- Gagné-Bourque, F.; Bertrand, A.; Claessens, A.; Aliferis, K.A.; Jabaji, S. Alleviation of Drought Stress and Metabolic Changes in Timothy (Phleum pratense L.) Colonized with Bacillus subtilis B26. Front. Plant Sci. 2016, 7, 584. [Google Scholar] [CrossRef] [PubMed]
- Vurukonda, S.S.K.P.; Vardharajula, S.; Shrivastava, M.; SkZ, A. Enhancement of drought stress tolerance in crops by plant growth promoting rhizobacteria. Microbiol. Res. 2016, 184, 13–24. [Google Scholar] [CrossRef] [PubMed]
- Kunert, K.J.; Vorster, B.J.; Fenta, B.A.; Kibido, T.; Dionisio, G.; Foyer, C.H. Drought Stress Responses in Soybean Roots and Nodules. Front. Plant Sci. 2016, 7. [Google Scholar] [CrossRef]
- Miller, G.; Suzuki, N.; Ciftci-Yilmaz, S.; Mittler, R. Reactive oxygen species homeostasis and signalling during drought and salinity stresses. Plant Cell Environ. 2010. [Google Scholar] [CrossRef]
- Choudhury, F.K.; Rivero, R.M.; Blumwald, E.; Mittler, R. Reactive oxygen species, abiotic stress and stress combination. Plant J. 2017, 90, 856–867. [Google Scholar] [CrossRef]
- Rajasheker, G.; Jawahar, G.; Jalaja, N.; Kumar, S.A.; Kumari, P.H.; Punita, D.L.; Karumanchi, A.R.; Reddy, P.S.; Rathnagiri, P.; Sreenivasulu, N.; et al. Role and regulation of osmolytes and ABA interaction in salt and drought stress tolerance. In Plant Signaling Molecules: Role and Regulation under Stressful Environments; Woodhead Publishing: Cambridge, UK, 2019; ISBN 9780128164518. [Google Scholar]
- Sharma, A.; Shahzad, B.; Kumar, V.; Kohli, S.K.; Sidhu, G.P.S.; Bali, A.S.; Handa, N.; Kapoor, D.; Bhardwaj, R.; Zheng, B. Phytohormones regulate accumulation of osmolytes under abiotic stress. Biomolecules 2019, 9, 285. [Google Scholar] [CrossRef]
- Bagri, D.S.; Upadhyaya, D.C.; Kumar, A.; Upadhyaya, C.P. Overexpression of PDX-II gene in potato (Solanum tuberosum L.) leads to the enhanced accumulation of vitamin B6 in tuber tissues and tolerance to abiotic stresses. Plant Sci. 2018. [Google Scholar] [CrossRef]
- Kumar, A.; Dubey, A. Rhizosphere microbiome: Engineering bacterial competitiveness for enhancing crop production. J. Adv. Res. 2020, 24, 337–352. [Google Scholar] [CrossRef] [PubMed]
- Ashraf, M.; Akram, N.A.; Al-Qurainy, F.; Foolad, M.R. Drought Tolerance. Roles of Organic Osmolytes, Growth Regulators, and Mineral Nutrients. Adv. Agron. 2011, 111, 249–296. [Google Scholar] [CrossRef]
- Hare, P.D.; Cress, W.A.; Van Staden, J. Dissecting the roles of osmolyte accumulation during stress. Plant Cell Environ. 1998, 21, 535–553. [Google Scholar] [CrossRef]
- Bakker, P.A.H.M.; Berendsen, R.L.; Doornbos, R.F.; Wintermans, P.C.A.; Pieterse, C.M.J. The rhizosphere revisited: Root microbiomics. Front. Plant Sci. 2013, 4, 165. [Google Scholar] [CrossRef] [PubMed]
- Sarma, R.K.; Saikia, R. Alleviation of drought stress in mung bean by strain Pseudomonas aeruginosa GGRJ21. Plant Soil 2014, 377, 111–126. [Google Scholar] [CrossRef]
- Rho, H.; Hsieh, M.; Kandel, S.L.; Cantillo, J.; Doty, S.L.; Kim, S.H. Do Endophytes Promote Growth of Host Plants Under Stress? A Meta-Analysis on Plant Stress Mitigation by Endophytes. Microb. Ecol. 2018. [Google Scholar] [CrossRef]
- Dubey, A.; Malla, M.A.; Kumar, A.; Dayanandan, S.; Khan, M.L. Plants endophytes: Unveiling hidden agenda for bioprospecting toward sustainable agriculture. Crit. Rev. Biotechnol. 2020, 40, 1210–1231. [Google Scholar] [CrossRef]
- Tippmann, H.F.; Schlüter, U.; Collinge, D. Common themes in biotic and abiotic stress signalling in plants. In Floriculture, Ornamental and Plant Biotechnology; Global Science Books: Ikenobe, Japan, 2006; pp. 52–63. [Google Scholar]
- Atkinson, N.J.; Urwin, P.E. The interaction of plant biotic and abiotic stresses: From genes to the field. J. Exp. Bot. 2012, 63, 3523–3543. [Google Scholar] [CrossRef]
- Nostar, O.; Ozdemir, F.; Bor, M.; Turkan, I.; Tosun, N. Combined effects of salt stress and cucurbit downy mildew (Pseudoperospora cubensis Berk. and Curt. Rostov.) infection on growth, physiological traits and antioxidant activity in cucumber (Cucumis sativus L.) seedlings. Physiol. Mol. Plant Pathol. 2013. [Google Scholar] [CrossRef]
- Ramegowda, V.; Senthil-Kumar, M. The interactive effects of simultaneous biotic and abiotic stresses on plants: Mechanistic understanding from drought and pathogen combination. J. Plant Physiol. 2015, 176, 47–54. [Google Scholar] [CrossRef]
- Dombrowski, J.E.; Hollenbeck, V.G.; Martin, R.C. Isolation and Identification of Bacterial Endophytes from Grasses along the Oregon Coast. Am. J. Plant Sci. 2017, 08, 574–601. [Google Scholar] [CrossRef][Green Version]
- Pandey, P.K.; Singh, S.; Singh, A.K.; Samanta, R.; Yadav, R.N.S.; Singh, M.C. Inside the plant: Bacterial endophytes and abiotic stress alleviation. J. Appl. Nat. Sci. 2019, 8, 1899–1904. [Google Scholar] [CrossRef]
- Zhang, Y.; Yu, X.; Zhang, W.; Lang, D.; Zhang, X.; Cui, G.; Zhang, X. Interactions between Endophytes and Plants: Beneficial Effect of Endophytes to Ameliorate Biotic and Abiotic Stresses in Plants. J. Plant Biol. 2019, 62, 1–13. [Google Scholar] [CrossRef]
- Chen, C.; Xin, K.; Liu, H.; Cheng, J.; Shen, X.; Wang, Y.; Zhang, L. Pantoea alhagi, a novel endophytic bacterium with ability to improve growth and drought tolerance in wheat. Sci. Rep. 2017, 7. [Google Scholar] [CrossRef]
- Yandigeri, M.S.; Meena, K.K.; Singh, D.; Malviya, N.; Singh, D.P.; Solanki, M.K.; Yadav, A.K.; Arora, D.K. Drought-tolerant endophytic actinobacteria promote growth of wheat (Triticum aestivum) under water stress conditions. Plant Growth Regul. 2012, 61, 411–420. [Google Scholar] [CrossRef]
- He, C.; Wang, W.; Hou, J. Plant Growth and Soil Microbial Impacts of Enhancing Licorice With Inoculating Dark Septate Endophytes Under Drought Stress. Front. Microbiol. 2019. [Google Scholar] [CrossRef]
- Namwongsa, J.; Jogloy, S.; Vorasoot, N.; Boonlue, S.; Riddech, N.; Mongkolthanaruk, W. Endophytic Bacteria Improve Root Traits, Biomass and Yield of Helianthus tuberosus L. Under normal and deficit water conditions. J. Microbiol. Biotechnol. 2019. [Google Scholar] [CrossRef] [PubMed]
- Saddique, M.A.B.; Ali, Z.; Khan, A.S.; Rana, I.A.; Shamsi, I.H. Inoculation with the endophyte Piriformospora indica significantly affects mechanisms involved in osmotic stress in rice. Rice 2018. [Google Scholar] [CrossRef] [PubMed]
- Vigani, G.; Rolli, E.; Marasco, R.; Dell’Orto, M.; Michoud, G.; Soussi, A.; Raddadi, N.; Borin, S.; Sorlini, C.; Zocchi, G.; et al. Root bacterial endophytes confer drought resistance and enhance expression and activity of a vacuolar H+-pumping pyrophosphatase in pepper plants. Environ. Microbiol. 2019, 21, 3212–3228. [Google Scholar] [CrossRef]
- Chourasiya, D.; Agnihotri, R.; Prakash, A.; Pal, K.K.; Sharma, M.P. Bioprotection of Soybean 666 Plants from Drought Stress by Application of Bacterial and Fungal Endophytes. In Root 667 Biology; Giri, B., Prasad, R., Varma, A., Eds.; Springer: Cham, Switzerland, 2018; Volume 52. [Google Scholar]
- Cao, L.; Qiu, Z.; Dai, X.; Tan, H.; Lin, Y.; Zhou, S. Isolation of endophytic actinomycetes from roots and leaves of banana (Musa acuminata) plants and their activities against Fusarium oxysporum f. sp. cubense. World J. Microbiol. Biotechnol. 2004, 20, 501–504. [Google Scholar] [CrossRef]
- Hameed, S.; Yasmin, S.; Malik, K.A.; Zafar, Y.; Hafeez, F.Y. Rhizobium, Bradyrhizobium and Agrobacterium strains isolated from cultivated legumes. Biol. Fertil. Soils 2004. [Google Scholar] [CrossRef]
- Kumar, U.; Panneerselvam, P.; Govindasamy, V.; Vithalkumar, L.; Senthilkumar, M.; Banik, A.; Annapurna, K. Long-term aromatic rice cultivation effect on frequency and diversity of diazotrophs in its rhizosphere. Ecol. Eng. 2017. [Google Scholar] [CrossRef]
- Sandhya, V.Z.A.S.; Grover, M.; Reddy, G.; Venkateswarlu, B. Alleviation of drought stress effects in sunflower seedlings by the exopolysaccharides producing Pseudomonas putida strain GAP-p45. Biol. Fertil. Soils 2009, 46, 17–26. [Google Scholar] [CrossRef]
- Pikovskaya, R.I. Mobilization of phosphorus in soil in connection with the vital activity of some microbial species. Microbiologia 1948, 17, 362–370. [Google Scholar]
- Fogg, D.N.; Wilkinson, N.T. The colorimetric determination of phosphorus. Biochem. J. 1958, 83, 406–414. [Google Scholar] [CrossRef]
- Gordon, S.A.; Weber, R.P. Colorimetric Estimation of Indoleacetic Acid. Plant Physiol. 1951. [Google Scholar] [CrossRef] [PubMed]
- Loaces, I.; Ferrando, L.; Scavino, A.F. Dynamics, Diversity and Function of Endophytic Siderophore-Producing Bacteria in Rice. Microb. Ecol. 2011. [Google Scholar] [CrossRef]
- Rahman, A.; Sitepu, I.R.; Tang, S.Y.; Hashidoko, Y. Salkowski’s reagent test as a primary screening index for functionalities of rhizobacteria isolated from wild dipterocarp saplings growing naturally on medium-strongly acidic tropical peat soil. Biosci. Biotechnol. Biochem. 2010. [Google Scholar] [CrossRef]
- Cappuccino, J.C.; Sherman, N. Microbiology: A Laboratory Manual; The Benjamin/Cummings Publishing Co., Inc.: Menlo Park, CA, USA, 1996; pp. 125–179. [Google Scholar]
- Dworkin, M.; Foster, J.W. Experiments with some microorganisms which utilize ethane and hydrogen. J. Bacteriol. 1958. [Google Scholar] [CrossRef]
- Penrose, D.M.; Glick, B.R. Methods for isolating and characterizing ACC deaminase-containing plant growth-promoting rhizobacteria. Physiol. Plant. 2003, 118, 10–15. [Google Scholar] [CrossRef]
- Honma, M.; Smmomura, T. Metabolism of 1-aminocyclopropane-1-carboxylic acid. Agric. Biol. Chem. 1978, 42. [Google Scholar] [CrossRef]
- Bradford, M.M. A rapid and sensitive method for the quantitation of microgram quantities of protein utilizing the principle of protein-dye binding. Anal. Biochem. 1976, 72, 248–254. [Google Scholar] [CrossRef]
- Lorck, H. Production of Hydrocyanic Acid by Bacteria. Physiol. Plant. 1948, 1, 142–146. [Google Scholar] [CrossRef]
- Dacre, J.C.; Sharpe, M.E. Catalase production by lactobacilli. Nature 1956, 178, 700. [Google Scholar] [CrossRef] [PubMed]
- Kasana, R.C.; Salwan, R.; Dhar, H.; Dutt, S.; Gulati, A. A rapid and easy method for the detection of microbial cellulases on agar plates using Gram’s iodine. Curr. Microbiol. 2008, 57, 503–507. [Google Scholar] [CrossRef] [PubMed]
- Babashpour, S.; Aminzadeh, S.; Farrokhi, N.; Karkhane, A.; Haghbeen, K. Characterization of a chitinase (Chit62) from Serratia marcescens B4A and its efficacy as a bioshield against plant fungal pathogens. Biochem. Genet. 2012, 50, 722–735. [Google Scholar] [CrossRef] [PubMed]
- Huang, H.C.; Hoes, J.A. Penetration and infection of Sclerotinia sclerotiorum by Coniothyrium minitans. Can. J. Bot. 2011, 54, 406–410. [Google Scholar] [CrossRef]
- Majeed, A.; Kaleem Abbasi, M.; Hameed, S.; Imran, A.; Rahim, N. Isolation and characterization of plant growth-promoting rhizobacteria from wheat rhizosphere and their effect on plant growth promotion. Front. Microbiol. 2015. [Google Scholar] [CrossRef]
- Eden, P.A.; Schmidt, T.M.; Blakemore, R.P.; Pace, N.R. Phylogenetic analysis of Aquaspirillum magnetotacticum using polymerase chain reaction-amplified 16S rRNA-specific DNA. Int. J. Syst. Bacteriol. 1991, 42, 324–325. [Google Scholar] [CrossRef]
- Islam, F.; Yasmeen, T.; Ali, Q.; Ali, S.; Arif, M.S.; Hussain, S.; Rizvi, H. Influence of Pseudomonas aeruginosa as PGPR on oxidative stress tolerance in wheat under Zn stress. Ecotoxicol. Environ. Saf. 2014, 104, 285–293. [Google Scholar] [CrossRef]
- Chakraborty, U.; Chakraborty, B.; Basnet, M. Plant growth promotion and induction of resistance in Camellia sinensis by Bacillus megaterium. J. Basic Microbiol. 2006, 46, 186–195. [Google Scholar] [CrossRef] [PubMed]
- Chakraborty, U.; Chakraborty, B.N.; Chakraborty, A.P.; Sunar, K.; Dey, P.L. Plant growth promoting rhizobacteria mediated improvement of health status of tea plants. Indian J. Biotechnol. 2013, 12, 20–31. [Google Scholar]
- Hashem, A.; Kumar, A.; Al-Dbass, A.M.; Alqarawi, A.A.; Al-Arjani, A.B.F.; Singh, G.; Farooq, M.; Abd_Allah, E.F. Arbuscular mycorrhizal fungi and biochar improves drought tolerance in chickpea. Saudi J. Biol. Sci. 2019, 26, 614–624. [Google Scholar] [CrossRef] [PubMed]
- Hepworth, C.; Doheny-Adams, T.; Hunt, L.; Cameron, D.D.; Gray, J.E. Manipulating stomatal density enhances drought tolerance without deleterious effect on nutrient uptake. New Phytol. 2015. [Google Scholar] [CrossRef]
- Paul, V.; Pandey, R.; Sharma, L.; Meena, R.C. Measurements of Stomatal Density and Stomatal Index on Leaf/Plant Surfaces. Div. Plant Physiol. 2017, 16–25. [Google Scholar] [CrossRef]
- Smart, R.E.; Bingham, G.E. Rapid Estimates of Relative Water Content. Plant Physiol. 1974. [Google Scholar] [CrossRef]
- Sahay, S.; Khan, E.; Gupta, M. Nitric oxide and abscisic acid protects against PEG-induced drought stress differentially in Brassica genotypes by combining the role of stress modulators, markers and antioxidants. Nitric Oxide Biol. Chem. 2019. [Google Scholar] [CrossRef]
- Hiscox, J.D.; Israelstam, G.F. A method for the extraction of chlorophyll without maceration from leaf tissue. Can. J. Bot. 1978, 57, 1332–1334. [Google Scholar] [CrossRef]
- Bates, L.S.; Waldren, R.P.; Teare, I.D. Rapid determination of free proline for water-stress studies. Plant Soil 1973, 39, 205–207. [Google Scholar] [CrossRef]
- Irigoyen, J.J.; Emerich, D.W.; Sanchez-Diaz, M. Water stress induced changes in concentrations of proline and total soluble sugars in nodulated alfalfa (Medicago sativa) plants. Physiol. Plant. 2003, 84, 55–60. [Google Scholar] [CrossRef]
- Velikova, V.; Yordanov, I.; Edreva, A. Oxidative stress and some antioxidant systems in acid rain-treated bean plants. Plant Sci. 2000, 151, 59–66. [Google Scholar] [CrossRef]
- Hodges, D.M.; DeLong, J.M.; Forney, C.F.; Prange, R.K. Improving the thiobarbituric acid-reactive-substances assay for estimating lipid peroxidation in plant tissues containing anthocyanin and other interfering compounds. Planta 1999, 207, 604–611. [Google Scholar] [CrossRef]
- Goswami, D.; Thakker, J.N.; Dhandhukia, P.C. Portraying mechanics of plant growth promoting rhizobacteria (PGPR): A review. Cogent Food Agric. 2016. [Google Scholar] [CrossRef]
- Hassan, S.E.D. Plant growth-promoting activities for bacterial and fungal endophytes isolated from medicinal plant of Teucrium polium L. J. Adv. Res. 2017, 8, 687–695. [Google Scholar] [CrossRef] [PubMed]
- Gilbert, S.; Xu, J.; Acosta, K.; Poulev, A.; Lebeis, S.; Lam, E. Bacterial Production of Indole Related Compounds Reveals Their Role in Association Between Duckweeds and Endophytes. Front. Chem. 2018, 6. [Google Scholar] [CrossRef]
- Naveed, M.; Mitter, B.; Reichenauer, T.G.; Wieczorek, K.; Sessitsch, A. Increased drought stress resilience of maize through endophytic colonization by Burkholderia phytofirmans PsJN and Enterobacter sp. FD17. Environ. Exp. Bot. 2014, 97, 30–39. [Google Scholar] [CrossRef]
- Singh Gusain, Y.; Singh, U.S.; Sharma, A.K. Bacterial mediated amelioration of drought stress in drought tolerant and susceptible cultivars of rice (Oryza sativa L.). Afr. J. Biotechnol. 2015, 14, 764–773. [Google Scholar] [CrossRef]
- Kanwal, S.; Ilyas, N.; Batool, N.; Arshad, M. Amelioration of drought stress in wheat by combined application of PGPR, compost, and mineral fertilizer. J. Plant Nutr. 2017, 40, 1250–1260. [Google Scholar] [CrossRef]
- Wei, Y.; Zhao, Y.; Fan, Y.; Lu, Q.; Li, M.; Wei, Q.; Zhao, Y.; Cao, Z.; Wei, Z. Impact of phosphate-solubilizing bacteria inoculation methods on phosphorus transformation and long-term utilization in composting. Bioresour. Technol. 2017, 241, 134–141. [Google Scholar] [CrossRef]
- Glick, B.R. Bacteria with ACC deaminase can promote plant growth and help to feed the world. Microbiol. Res. 2014, 169, 30–39. [Google Scholar] [CrossRef]
- Danish, S.; Zafar-Ul-Hye, M.; Mohsin, F.; Hussain, M. ACC-deaminase producing plant growth promoting rhizobacteria and biochar mitigate adverse effects of drought stress on maize growth. PLoS ONE 2020, 15, e230615. [Google Scholar] [CrossRef] [PubMed]
- Gontia-Mishra, I.; Sapre, S.; Sharma, A.; Tiwari, S. Amelioration of drought tolerance in wheat by the interaction of plant growth-promoting rhizobacteria. Plant Biol. 2016, 18, 992–1000. [Google Scholar] [CrossRef] [PubMed]
- Barnawal, D.; Singh, R.; Singh, R.P. Role of Plant Growth Promoting Rhizobacteria in Drought Tolerance: Regulating Growth Hormones and Osmolytes. PGPR Amelior. Sustain. Agric. 2019, 107–128. [Google Scholar] [CrossRef]
- Barnawal, D.; Bharti, N.; Pandey, S.S.; Pandey, A.; Chanotiya, C.S.; Kalra, A. Plant growth-promoting rhizobacteria enhance wheat salt and drought stress tolerance by altering endogenous phytohormone levels and TaCTR1/TaDREB2 expression. Physiol. Plant. 2017, 161, 502–514. [Google Scholar] [CrossRef] [PubMed]
- Karmel Reetha, A.; Pavani, S.L.; Mohan, S. Hydrogen Cyanide Production Ability by bacterial antagonist and their Antibiotics Inhibition Potential on Macrophomina phaseolina (Tassi.) Goid. Int. J. Curr. Microbiol. Appl. Sci. 2014, 3, 172–178. [Google Scholar]
- Carro, L.; Menéndez, E. Knock, knock-let the bacteria. In Molecular Aspects of Plant Beneficial Microbes in Agriculture; Academic Press: Cambridge, MA, USA, 2020. [Google Scholar]
- Mafakheri, A.; Siosemardeh, A.; Bahramnejad, B.; Struik, P.C.; Sohrabi, E. Effect of drought stress on yield, proline and chlorophyll contents in three chickpea cultivars. Aust. J. Crop Sci. 2010, 4, 580–585. [Google Scholar]
- Mohammadkhani, N.; Heidari, R. Drought-induced Accumulation of Soluble Sugars and Proline in Two Maize Varieties. World Appl. Sci. J. 2008, 3, 448–453. [Google Scholar]
- Yamada, M.; Morishita, H.; Urano, K.; Shiozaki, N.; Yamaguchi-Shinozaki, K.; Shinozaki, K.; Yoshiba, Y. Effects of free proline accumulation in petunias under drought stress. J. Exp. Bot. 2005, 56, 1975–1981. [Google Scholar] [CrossRef]
- Grover, M.; Nain, L.; Singh, S.B.; Saxena, A.K. Molecular and biochemical approaches for characterization of antifungal trait of a potent biocontrol agent Bacillus subtilis RP24. Curr. Microbiol. 2010, 60, 99–106. [Google Scholar] [CrossRef]
- Anjum, S.A.; Xie, X.Y.; Wang, L.C.; Saleem, M.F.; Man, C.; Lei, W. Morphological, physiological and biochemical responses of plants to drought stress. Afr. J. Agric. Res. 2011, 6, 2026–2032. [Google Scholar]
- Hashem, A.; Abd_Allah, E.F.; Alqarawi, A.A.; Radhakrishnan, R.; Kumar, A. Plant defense approach of Bacillus subtilis (BERA 71) against Macrophomina phaseolina (Tassi) Goid in mung bean. J. Plant Interact. 2017, 12, 390–401. [Google Scholar] [CrossRef]
- Sandhya, V.; Shrivastava, M.; Ali, S.Z.; Sai Shiva Krishna Prasad, V. Endophytes from maize with plant growth promotion and biocontrol activity under drought stress. Russ. Agric. Sci. 2017. [Google Scholar] [CrossRef]
- Kandel, S.; Joubert, P.; Doty, S. Bacterial Endophyte Colonization and Distribution within Plants. Microorganisms 2017, 5, 77. [Google Scholar] [CrossRef] [PubMed]

| Fungal Strain/Bacterial Strain | Alternaria alternata | Fusarium oxysporum | Macrophomina phaseolina |
|---|---|---|---|
| AKAD A1-1 | 96 ± 2.8% | 98.5 ± 1.3% | No inhibition observed |
| AKAD A1-2 | No inhibition observed | 97 ± 2.27% | No inhibition observed |
| AKAD A1-16 | 40.5 ± 1.27% | 98 ± 1.67% | 90 ± 1.45% |
| Morphological Parameters | |||||
|---|---|---|---|---|---|
| Treatment | Shoot Length (cm) | Root Length (cm) | Plant Fresh Weight (g) | Plant Dry Weight (g) | Average Stomatal Density/Unit Area |
| T1 | 35.3 ± 2.04 b | 12.45 ± 0.8 b | 2.22 ± 0.10 b | 0.85 ± 0.03 b | 59.33 ± 2.34 b |
| T2 | 45.10 ± 1.42 d | 15.74 ± 1.2 d | 2.74 ± 0.125 d | 1.27 ± 0.02 d | 80.5 ± 1.67 e |
| T3 | 47.6 ± 1.01 e | 18.05 ± 1.5 f | 3.51 ± 0.2 g | 1.48 ± 0.01 f | 88.4 ± 2.3 f |
| T4 | 52.03 ± 2.19 g | 22.03 ± 1.3 h | 3.89 ± 0.14 h | 1.60 ± 0.05 h | 90.5 ± 2.56 f |
| T5 | 28.5 ± 1.50 a | 10.5 ± 0.78 a | 1.69 ± 0.03 a | 0.65 ± 0.03 a | 46.45 ± 1.45 a |
| T6 | 41.49 ± 2.8 c | 13.83 ± 0.69 c | 2.4 ± 0.12 c | 1.09 ± 0.02 c | 67.5 ± 2.0 c |
| T7 | 43.31 ± 1.9 cd | 17.16 ± 0.76 e | 2.9 ± 0.14 e | 1.35 ± 0.04 e | 71.5 ± 2.5 d |
| T8 | 49.98 ± 1.5 f | 19.26 ± 1.2 fg | 3.05 ± 0.2 ef | 1.51 ± 0.02 g | 78.4 ± 1.4 e |
| Biochemical Parameters | |||||||
|---|---|---|---|---|---|---|---|
| Treatment | LRWC % | Total Chlorophyll (mg g−1 FW) | Total Soluble Sugar (mg g−1 FW) | Proline (mg g−1 FW) | Protein (µg g−1 FW) | MDA (nmol g−1 FW) | H2O2 (mM g−1 FW) |
| T1 | 86.18 ± 1.8 bc | 1.73 ± 0.03 ab | 2.61 ± 0.04 a | 20.67 ± 1.8 a | 167 ± 3.13 a | 16.9 ± 1.7 d | 3.76 ± 0.05 c |
| T2 | 90.26 ± 2.4 cde | 2.13 ± 0.02 cd | 2.79 ± 0.08 b | 24.7 ± 0.9 b | 204 ± 3.4 c | 14.6 ± 0.5 cd | 2.7 ± 0.08 b |
| T3 | 91.81 ± 2.5 de | 2.4 ± 0.03 de | 2.84 ± 0.05 bc | 27.6 ± 0.62 bc | 209.6 ± 1.5 d | 13.2 ± 0.73 bc | 2.35 ± 0.05 a |
| T4 | 93.86 ± 2.4 bcd | 2.54 ± 0.02 e | 3.24 ± 0.02 d | 30.52 ± 0.7 c | 218.3 ± 2.0 e | 11.2 ± 1.0 a | 2.16 ± 0.04 a |
| T5 | 60.71 ± 3.33 a | 1.40 ± 0.04 a | 2.89 ± 0.01 c | 34.29 ± 1.4 d | 190.2 ± 2.1 b | 77.2 ± 2.30 h | 5.28 ± 0.25 d |
| T6 | 83.5 ± 1.5 b | 1.80 ± 0.05 bc | 3.32 ± 0.09 d | 40.3 ± 1.5 e | 231.3 ± 1.5 f | 54.13 ± 1.8 g | 3.38 ± 0.07 c |
| T7 | 87.18 ± 2.02 e | 1.85 ± 0.03 bc | 3.76 ± 0.06 e | 45.06 ± 1.6 f | 237.6 ± 1.5 g | 50.3 ± 1.57 f | 2.73 ± 0.14 b |
| T8 | 90.1 ± 1.86 cde | 2.37 ± 0.04 de | 4.12 ± 0.12 f | 57.2 ± 1.9 g | 240.2 ± 1.7 h | 48.9 ± 1.70 e | 2.34 ± 0.05 a |
| Correlation | Morphological Parameters | Biochemical Parameters | Oxidative Stress | ||||||||
|---|---|---|---|---|---|---|---|---|---|---|---|
| SL | RL | PFW | PDW | RWC | CHL | SUG | PRO | PROT | MDA | H2O2 | |
| SL | 1 | 0.913 ** | 0.940 ** | 0.930 ** | 0.778 ** | 0.902 ** | 0.423 * | 0.250 | 0.550 ** | −0.497 * | −0.872 ** |
| RL | 1 | 0.946 ** | 0.932 ** | 0.802 ** | 0.911 ** | 0.483 * | 0.339 | 0.679 ** | −0.440 * | −0.931 ** | |
| PFW | 1 | 0.970 ** | 0.824 ** | 0.892 ** | 0.449 * | 0.241 | 0.577 ** | −0.545 ** | −0.937 ** | ||
| PDW | 1 | 0.781 ** | 0.834 ** | 0.573 ** | 0.371 | 0.683 ** | −0.411 * | −0.906 ** | |||
| RWC | 1 | 0.801 ** | 0.195 | 0.017 | 0.380 | −0.709 ** | −0.936 ** | ||||
| CHL | 1 | 0.243 | 0.077 | 0.389 | −0.655 ** | −0.886 ** | |||||
| SUG | 1 | 0.937 ** | 0.827 ** | −0.419 * | −0.367 | ||||||
| PRO | 1 | 0.797 ** | −0.607 ** | −0.192 | |||||||
| PROT | 1 | −0.295 | −0.565 ** | ||||||||
| MDA | 1 | 0.597 ** | |||||||||
| H2O2 | 1 | ||||||||||
Publisher’s Note: MDPI stays neutral with regard to jurisdictional claims in published maps and institutional affiliations. |
© 2021 by the authors. Licensee MDPI, Basel, Switzerland. This article is an open access article distributed under the terms and conditions of the Creative Commons Attribution (CC BY) license (http://creativecommons.org/licenses/by/4.0/).
Share and Cite
Dubey, A.; Saiyam, D.; Kumar, A.; Hashem, A.; Abd_Allah, E.F.; Khan, M.L. Bacterial Root Endophytes: Characterization of Their Competence and Plant Growth Promotion in Soybean (Glycine max (L.) Merr.) under Drought Stress. Int. J. Environ. Res. Public Health 2021, 18, 931. https://doi.org/10.3390/ijerph18030931
Dubey A, Saiyam D, Kumar A, Hashem A, Abd_Allah EF, Khan ML. Bacterial Root Endophytes: Characterization of Their Competence and Plant Growth Promotion in Soybean (Glycine max (L.) Merr.) under Drought Stress. International Journal of Environmental Research and Public Health. 2021; 18(3):931. https://doi.org/10.3390/ijerph18030931
Chicago/Turabian StyleDubey, Anamika, Diksha Saiyam, Ashwani Kumar, Abeer Hashem, Elsayed Fathi Abd_Allah, and Mohammed Latif Khan. 2021. "Bacterial Root Endophytes: Characterization of Their Competence and Plant Growth Promotion in Soybean (Glycine max (L.) Merr.) under Drought Stress" International Journal of Environmental Research and Public Health 18, no. 3: 931. https://doi.org/10.3390/ijerph18030931
APA StyleDubey, A., Saiyam, D., Kumar, A., Hashem, A., Abd_Allah, E. F., & Khan, M. L. (2021). Bacterial Root Endophytes: Characterization of Their Competence and Plant Growth Promotion in Soybean (Glycine max (L.) Merr.) under Drought Stress. International Journal of Environmental Research and Public Health, 18(3), 931. https://doi.org/10.3390/ijerph18030931

